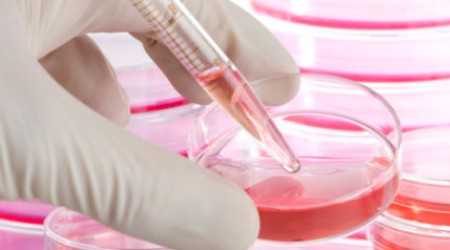

Staminali del cordone ombelicale: primo trapianto su una bambina italiana affetta da paralisi cerebrale
Mag 25, 2013 - redazione
Ha 3 anni e mezzo e grazie alle staminali conservate privatamente è stata inserita in un trial clinico negli USA. «Le terapie rigenerative aprono nuove frontiere e ridanno speranza», afferma Irene Martini, direttore scientifico di SmartBank
Staminali del cordone ombelicale: primo trapianto su una bambina italiana affetta da paralisi cerebrale
Ha 3 anni e mezzo e grazie alle staminali conservate privatamente è stata inserita in un trial clinico negli USA. «Le terapie rigenerative aprono nuove frontiere e ridanno speranza», afferma Irene Martini, direttore scientifico di SmartBank
La speranza di una bambina di 3 anni e mezzo affetta da paralisi cerebrale fin dalla nascita è affidata alle cellule staminali del suo cordone ombelicale. È lei la prima italiana sottoposta a trapianto con cellule cordonali autologhe. L’intervento è stato effettuato il 21 maggio al Medical Center della Duke University (Durham, North Carolina – USA) all’interno del protocollo scientifico coordinato dalla pediatra Joanne Kurtzberg. La piccola è stata selezionata a livello mondiale tra i 4.700 bimbi affetti da paralisi cerebrale i cui genitori, scegliendo di conservare privatamente le cellule staminali del cordone ombelicale, hanno voluto dare ai figli un importante patrimonio cellulare. «Si tratta del primo caso in Italia», afferma Irene Martini, direttore scientifico di SmartBank, la banca delle cellule staminali cui la famiglia si è affidata per la conservazione delle cellule cordonali della figlia. «È il primo caso di trapianto con staminali cordonali autologhe che vede interessato un italiano. Contrariamente a quanti sostengono l’inutilità di avere a disposizione le proprie staminali cordonali, conservare privatamente le cellule del cordone ombelicale si rivela una grande opportunità».
La bambina interessata è stata colpita alla nascita da ipossia che le ha provocato una paralisi cerebrale. Per quanto siano situazioni non prevedibili, questi non sono casi così rari: si stima infatti che circa un neonato ogni 1.000 possa riscontrare questi problemi. La paralisi cerebrale è un disturbo definito come persistente, in quanto la lesione a carico del cervello non è suscettibile di “guarigione” in senso stretto. I malati perdono la capacità di parlare e muoversi normalmente e finora l’unica possibilità a loro disposizione sembrava essere limitata al tentativo di rilassare i muscoli con continue terapie fisiche, farmacologiche e riabilitative, con una funzione di sostegno e non curativa.
«Venuti a conoscenza di questa situazione, in accordo con i genitori ci siamo attivati affinché la piccola potesse essere inserita nel trial clinico della Duke University controllato dalla FDA che si basa proprio sull’utilizzo delle staminali autologhe», spiega Martini. «I ricercatori coordinati da Kurtzberg hanno messo a punto una terapia che permette di correggere in modo innovativo le alterazioni strutturali e biochimiche di questa patologia invalidante. Le cellule cordonali autologhe possono agire in modo multiplo: ridurre l’aspetto infiammatorio e rilasciare fattori di crescita che hanno un’attività rigenerativa, prevedendo così un recupero motorio e cognitivo». I parametri della piccola rientravano nei parametri previsti dal protocollo scientifico. Anche le staminali cordonali raccolte tre anni e mezzo fa e conservate attraverso SmartBank nei laboratori dell’Università di Plymouth sono risultate idonee all’utilizzo, ovvero rispettose di tutte le rigorose caratteristiche di qualità richieste. Così la bambina è stata ammessa al trial clinico, rientrando in un campione di 60 bambini di età compresa da 1 a 6 anni, selezionati a livello mondiale.
«Il trapianto, che è un’infusione delle staminali, è andato bene. Elevate la qualità e la quantità delle cellule della piccola -riferisce il direttore scientifico di Smartbank-. Secondo Kurtzberg, proprio grazie a questo ottimo patrimonio cellulare, ci sono delle buone speranze per questa bambina: significativi miglioramenti sono attesi tra circa 18 mesi, ma c’è la possibilità che segnali positivi possano essere visibili già tra tre mesi. Questo trapianto non solo dimostra l’importanza che la comunità scientifica internazionale attribuisce alle cellule staminali del cordone ombelicale conservate privatamente, ma coinvolge direttamente anche l’Italia in una ricerca scientifica internazionale dalla quale si potranno ottenere importanti indicazioni di cura».
SmartBank – (www.smartbank.it) è la prima banca italiana ad aver dato la possibilità ai genitori di conservare privatamente le cellule staminali del cordone ombelicale. È stata fortemente voluta dal suo direttore scientifico, la dottoressa Irene Martini, l’unica rappresentante italiana ammessa al Board della Fondazione Parent’s Guide to Cord Blood, punto di riferimento internazionale sia per la donazione pubblica che per la conservazione privata. Il laboratorio partner di SmartBank è Biovault (www.biovaulttechnical.co.uk/) banca di tessuti, da oltre 10 anni specializzata nel processare e conservare cellule staminali da midollo osseo, sangue periferico, cordone ombelicale; con la capacità di conservare più di un milione di campioni, più recentemente ha ampliato i propri accreditamenti anche al banking di tessuti adiposi, tendinei, della cornea, della pelle, del femore, di valvole cardiache e di sperma.